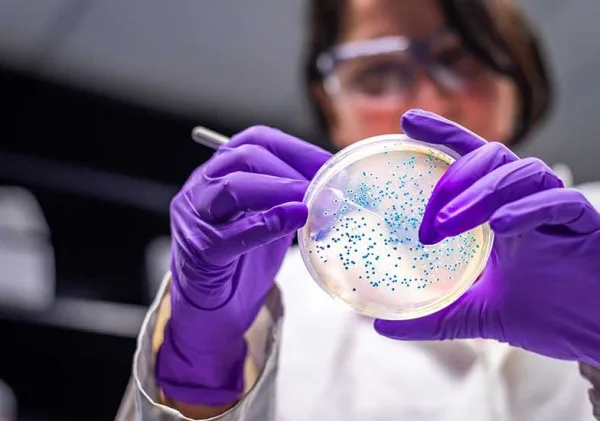
Rasanya Juara, Tapi Amankah? Pentingnya Analisis Mikrobiologi untuk Keamanan Pangan

Dan terakhir kita juga perlu melakukan analisis indeks glikemik (GI), yang bertujuan untuk melihat kandungan gula dalam gorengan, yang dapat memengaruhi metabolisme serta menyebabkan resiko diabetes.
Kesimpulan
Dari hasil analisis-analisis yang telah dilakukan, berbagai macam kandungannya perlu dibandingkan dengan peraturan yang mengatur jumlah atau batas konsumsi harian kandungan lemak yang dapat dikonsumsi, seperti pada Peraturan Menteri Kesehatan (PerMenKes) nomor 30 tahun 2013, yang menyatakan bahwa “...Lemak total lebih dari 67 gram per orang per hari berisiko hipertensi, stroke, diabetes, dan serangan jantung”. Sehingga dari hasil analisis ini dapat memberikan pengetahuan dan pengawasan diri terhadap dampak konsumsi dari makanan- makanan yang renyah, dengan proses penggorengan menggunakan minyak berulang-ulang atau lebih.
Daftar Pustaka:
Sinaga, L. R.
V., Munthe, S. A., Bangun, H. A., dan Utami, M. P. 2019.
Penelitian Kualitatif untuk Mengidentifikasi Kebiasaan Makan Masyarakat yang Berkaitan dengan Hipertensi Esensial di Desa Tualang Lama Kecamatan Deleng Pokhkisen Kabupaten Aceh Tenggara tahun 2018. Akrab Juara: Jurnal Ilmu-ilmu Sosial, Vol. 4(2), 147-163.
Jamaluddin, J. 2018. Pengolahan Aneka Kerupuk Dan Keripik Bahan Pangan.
Makassar: UNM Press.
Ardhany, S. D., dan Lamsiyah, L. 2018.
Tingkat Pengetahuan Pedagang Warung Tenda Di Jalan Yos Sudarso Palangkaraya Tentang Bahaya Penggunaan Minyak Jelantah Bagi Kesehatan. Jurnal Surya Medika (JSM), Vol. 3(2), 62-68.
Purhadi, P., Purnanto, N. T., dan Natassia, K. 2020.